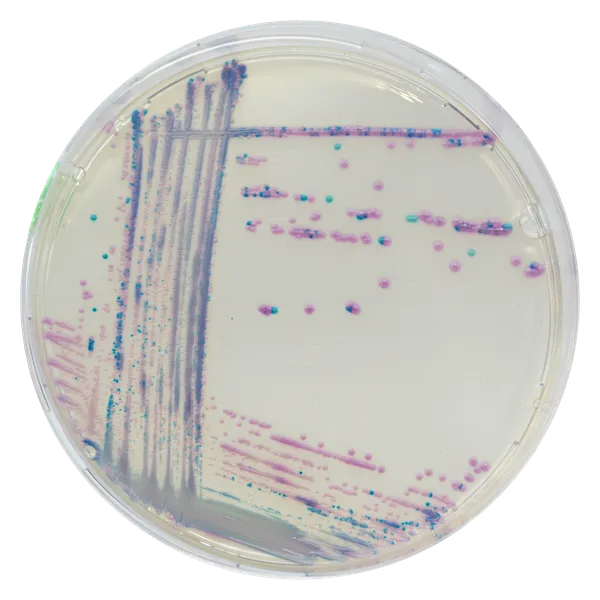
CHROMagar™ Streptococcus

Hình thái khuẩn lạc

S. agalactiae
Màu xanh

Enterococcus
Màu nâu nhạt đến tím

S. uberis
Màu xanh đến xanh kim loại
Hiệu năng
Hiệu năng
Loài Streptococci từ môi trường được coi là những tác nhân chính gây viêm bầu vú do chúng thường gây ra các đợt nhiễm trùng kéo dài và sự nhiễm khuẩn tế bào soma cao. CHROMagar™ Streptococcus được thiết kế để hỗ trợ chẩn đoán viêm bầu vú, đặc biệt là giúp phân biệt các loài có liên quan trong nhiễm trùng vú.
Có những ứng dụng khác mà CHROMagar™ Streptococcus cũng đã tỏ ra là một công cụ hữu ích để phân biệt Streptococci trong các mẫu có nhiều hệ vi khuẩn phức tạp.
1. Rất chọn lọc: dành cho nhóm Streptococcus.
2. Phân biệt màu sắc:cho phép phân biệt màu sắc rõ ràng của các loài Streptococci khác nhau.
3. Kết quả nhanh chóng: kết quả sau 24 giờ ủ.
4. Dễ dàng diễn giải :CHROMagar™ Streptococcus phù hợp với mẫu có nhiều vi khuẩn.

Kết hợp hiệu năng công nghệ của chúng tôi, đĩa ba phân khu này chứa CHROMagar™ Staphylococcus, CHROMagar™ Streptococcus và CHROMagar™ Mastitis GN.
Với độ đặc hiệu cao của ba môi trường CHROMagar™, công cụ này cho phép phổ phân biệt rất rộng của các vi sinh vật, đặc biệt quan trọng trong các ma trận phức tạp như mẫu sữa từ các trường hợp viêm bầu vú hoặc mẫu pháp y động vật.
Đĩa đã đổ sẵn hiện có ở một số quốc gia như Châu Âu, Hoa Kỳ và Brazil. Liên hệ với nhà phân phối địa phương của bạn để biết thêm thông tin.
Thành phần

Tài liệu kỹ thuật
Công bố khoa học
2016
Evaluation of an On-Farm Culture System (Accumast) for Fast Identification of Milk Pathogens Associated with Clinical Mastitis in Dairy Cows
? Publication

Xem thêm